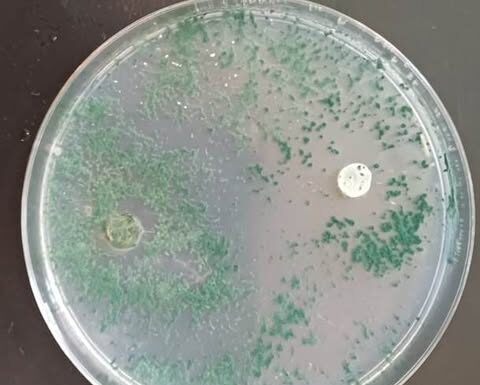
NUEVOS CONOCIMIENTOS Una técnica natural con hongos “protectores” podría impulsar el cultivo del Caupí

Alejandro Camors, estudiante de Ciencias Biológicas de la UNNE, investiga cómo proteger esta nutritiva legumbre usando microorganismos que actúan como "guardianes" de las plantas....
La doctora Claudia Gómez presentó un estudio que actualiza y precisa la delimitación de las cuencas hidrográficas chaqueñas, reduciendo de 13 a 10 las...
Un estudio de la UNNE y Conicet logró avances preliminares en el ajuste de herramientas de análisis que permitan diferenciar las mieles de abejas...
Bajo la dirección de las doctoras Bárbara De Biasio y Graciela Esquivel, la estudiante María Victoria Busellato, lleva adelante una investigación que combina análisis...
Como un aporte a la detección temprana, precisa y rápida de enfermedades ginecológicas, el Laboratorio de Medicina Genómica, de la Facultad de Medicina de...
Celeste Milena Sabaj, becaria de la Secretaría General de Ciencia y Técnica de la UNNE, analiza por qué los departamentos en torre de la...
En la revista internacional “Biochimie” se publicaron avances de una investigación de la UNNE y CONICET que identificó el potencial de dos moléculas de...
Combinando imágenes satelitales y trabajo de campo, una estudiante de Licenciatura en Geografía analiza cómo la variabilidad climática y la dinámica poblacional afectan a...
En el marco de un proyecto que integra robótica móvil, inteligencia artificial y agricultura de precisión, investigadores de la Facultad de Ingeniería de la...
En el marco de acciones para el aprovechamiento de especies nativas de bambú o tacuara como material constructivo, la Facultad de Arquitectura y Urbanismo...